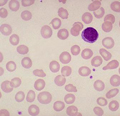
Νέα φαρμακευτική ουσία στην αντιμετώπιση της νεφρικής αναιμίας

Νέα φαρμακευτική ουσία αλλάζει την αντιμετώπιση του εμφράγματος
Με νέα αποτελεσματικότερα «όπλα» εμπλουτίζεται συνεχώς η θεραπευτική φαρέτρα των ιατρών απέναντι στη σύγχρονη κοινωνική «μάστιγα» που ακούει στο όνομα στεφανιαία νόσος. Τα αποτελέσματα της κλινικής μελέτης PLATO καταδεικνύουν ότι η τικαγρελόλη μειώνει σημαντικά τη θνησιμότητα από οξέα στεφανιαία σύνδρομα.

Αριθμός Πιστοποίησης Μ.Η.Τ.232442
Αριθμός Πιστοποίησης Μ.Η.Τ.232442